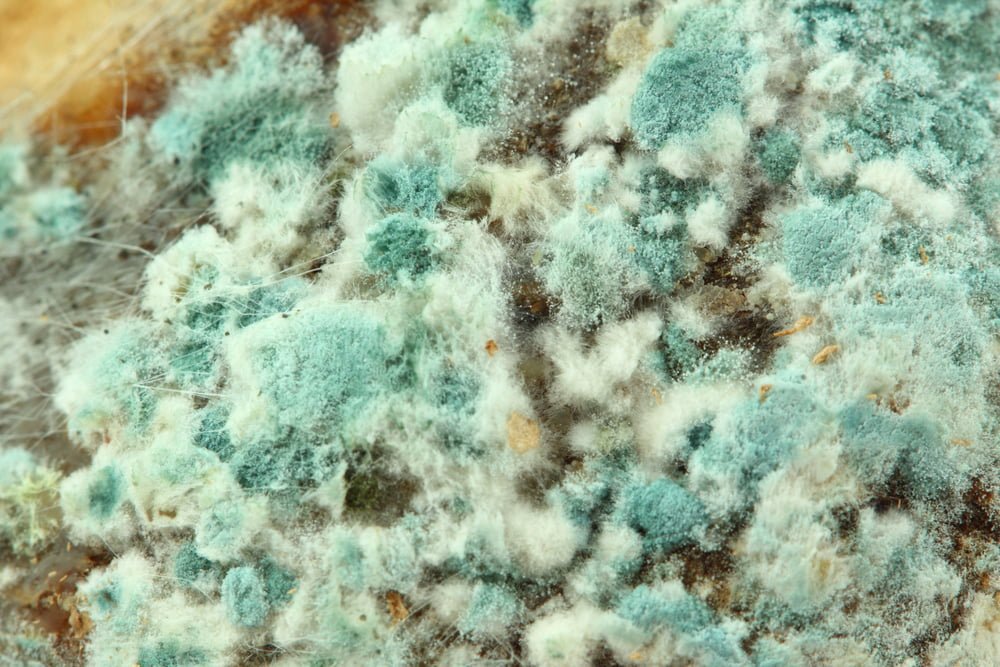
Ozone Therapy for Mold Toxicity

Ozone Therapy for Mold Toxicity
Ozone is not just a layer in the sky that protects us from the sun’s harmful ultraviolet rays- it’s a molecule that exists right here on earth every time lightning strikes. The air we breathe is O2, which consists of two oxygen molecules that share a group of electrons and has no free bonds, making it stable. When lightning occurs, it causes the O2 oxygen molecules in the air to split apart forming individual, unstable oxygen atoms. These single molecules, written as O, are unstable and want a pair bond, so they will seek out another single oxygen molecule in an attempt to stabilize and re-create O2. In this process, there are groupings of three oxygen molecules that combine making O3, also known as ozone. Since the electrons in the O3 molecule are an odd number and not paired up, the ozone only lasts for a short time before it loses an oxygen molecule and reverts back to O2. That single oxygen molecule that is cast off will find another single oxygen molecule and combine to form a new O2 molecule. The smell that you can sometimes observe after a storm is the smell of ozone in the air created by the electrocurrent in a lightning strike splitting apart oxygen molecules. However, it is quickly broken down by other atmospheric reactions, so it does not accumulate in large quantities. This is a good thing, since we cannot inhale ozone without it irritating our throat and lungs. We can, however, intake ozone in other ways that provide tremendous beneficial effects. Since we can’t capture lightning in a bottle, ozone can be made artificially using an ozone generator. This machine employs ultraviolet light or corona discharge to act like lightning and break apart oxygen molecules to form ozone gas. Just like in nature, there is a limited time to use O3 before it reverts back into O2. The ozone created by these machines is used for a variety of commercial, residential, industrial, and medical purposes, including: cleaning and sterilizing equipment; removing odors, bacteria, and other pollutants from indoor environments; in water treatment to remove contaminants and disinfect water; and in and in food processing to extend shelf life.
Ozone was first used as an antimicrobial agent in 1873, and in 1885 the first textbook on the medical application of ozone was published in 1885 by Dr. Charles J. Kenworth. The medical applications of ozone began in the early 1900s, when ozone therapy showed a positive therapeutic effect for many conditions, such as wound healing, tuberculosis, anemia, tinnitus, whooping cough, asthma, bronchitis, pneumonia, frostbite, and many others. There are a total of 50 clinical trials in the US that have or currently are examining the efficacy and mechanism of action for ozone therapy. Globally, ozone therapy is used therapeutically in Germany (which was the first country to manufacture and use medical ozonators), Switzerland, Italy, Russia, Cuba, Mexico, Brazil and Japan. Not only is it an effective treatment, but it is easy to use and administer, relatively inexpensive, and there are no side effects. Depending on the therapeutic application, ozone can act as anti-inflammatory, immune-modulator, bactericidal, virucidal, fungicidal, or analgesic as it activates “immune, anti-inflammatory signaling, proteasome, releases growth factors, improves blood circulation, and has antimicrobial activity, with potential effects on gut microbiota” (Scassellati et al., 2020). It truly is a super molecule!
The fungicidal properties are very important, since mold is a very common fungus that can be found everywhere in our built environment and thrives in damp environments. Whether it’s the sandwich we forgot about in the fridge, or the corners of our basement, we all have encountered mold at some point. It is especially common in houses built recently, as sheetrock, fiberboard, and gypsum board are mold breeding grounds if they experience water damage. If people are exposed to a large amount of mold over time, or are sensitive to mold, they can exhibit signs of mold toxicity, including respiratory problems, neurological symptoms, digestive issues, skin irritation, and flu-like symptoms. You can learn more about mold toxicityhere.
These symptoms are the result of mold producing a variety of toxins, called mycotoxins, which are released into the air and can be inhaled or ingested. Mycotoxins have various effects on our body’s system, ranging from mild to debilitating. The toxin overload creates inflammation and oxidative stress in the body, leading to damage of cells and tissues. In addition to mycotoxins, mold can also produce allergens and irritants that can trigger allergic reactions or respiratory symptoms. For people with weakened immune systems or pre-existing respiratory conditions, exposure to mold can be particularly harmful. This is where ozone can help! Ozone has many superpowers that are dose dependent: “high dosages stimulate severe oxidative stress resulting in inflammatory response and tissue injury, whereas low O3 concentrations induce a moderate oxidative eustress activating antioxidant pathways” (Galiè et al., 2019). Some of the mechanisms of action of ozone include:
- When ozone comes into contact with mold, it damages the cell walls, causing them to rupture and break apart in a process known as oxidation.
- Once inside the cell, ozone reacts with the DNA of mold, causing damage to the genetic material and preventing it from reproducing.
- Ozone stimulates the immune system by increasing cytokines, phagocytes, glutathione, N-R-F-2, and red blood cells that destroy the mold fungus.
- Ozone neutralizes harmful free radicals in our body, which reduces oxidative stress and inflammation, boosting our immune system.
- Ozone increases the supply of oxygen to our blood and organs, which supports cellular and immune health.
- Ozone therapy has a positive effect on platelets, cell mediated remodeling, and mitochondria structure.
For those suffering from mold toxicity, the first step is to remove and remediate any mold that you are exposed to. The second step is to support your body so it can detox from the mold and heal from the toxicity of this fungus. Ozone is a clinical proven way to help your body rid itself of unwanted microorganisms, heal damaged cells and tissues, and strengthen your immune system against its deleterious effects. It’s also safe and can be administered in many ways, including can be taken orally via ozonated water or capsules, applied topically, intravenously, or administered internally through insufflation. Recovering from mold toxicity requires a holistic approach, and ozone is an excellent modality to help lead these efforts.
References
Afsah-Hejri, L., Hajeb, P., & Ehsani, R. J. (2020). Application of ozone for degradation of mycotoxins in food: A review. Comprehensive reviews in food science and food safety, 19(4), 1777–1808. https://doi.org/10.1111/1541-4337.12594
Cisterna B, Costanzo M, Nodari A, Galiè M, Zanzoni S, Bernardi P, Covi V, Tabaracci G, Malatesta M. Ozone Activates the Nrf2 Pathway and Improves Preservation of Explanted Adipose Tissue In Vitro. Antioxidants (Basel). 2020 Oct 14;9(10):989. doi: 10.3390/antiox9100989. PMID: 33066365; PMCID: PMC7602229.
EPA. (n.d.). A Brief Guide to Mold, Moisture and Your Home. EPA. Retrieved April 12, 2023, from https://www.epa.gov/mold/brief-guide-mold-moisture-and-your-home#:~:text=Molds%20reproduce%20by%20means%20of,grow%20without%20water%20or%20moisture.
Galiè M, Covi V, Tabaracci G, Malatesta M. The Role of Nrf2 in the Antioxidant Cellular Response to Medical Ozone Exposure. Int J Mol Sci. 2019 Aug 17;20(16):4009. doi: 10.3390/ijms20164009. PMID: 31426459; PMCID: PMC6720777.
Juchniewicz H, Lubkowska A. Oxygen-Ozone (O2-O3) Therapy in Peripheral Arterial Disease (PAD): A Review Study. Ther Clin Risk Manag. 2020 Jun 29;16:579-594. doi: 10.2147/TCRM.S255247. PMID: 32636631; PMCID: PMC7334138.
Kuśka-Kiełbratowska, A., Wiench, R., Mertas, A., Bobela, E., Kiełbratowski, M., Lukomska-Szymanska, M., Tanasiewicz, M., & Skaba, D. (2022). Evaluation of the Sensitivity of Selected Candida Strains to Ozonated Water-An In Vitro Study. Medicina (Kaunas, Lithuania), 58(12), 1731. https://doi.org/10.3390/medicina58121731
Maslennikov, O., Kontirshchikova, C., & Gribkova, I. (2008). Ozone Therapy in Practice. Ministry of Health Services of the Russian Federation & The State Medical Academy of Nizhny Novgorod.
McKenzie, K. S., Sarr, A. B., Mayura, K., Bailey, R. H., Miller, D. R., Rogers, T. D., Norred, W. P., Voss, K. A., Plattner, R. D., Kubena, L. F., & Phillips, T. D. (1997). Oxidative degradation and detoxification of mycotoxins using a novel source of ozone. Food and chemical toxicology : an international journal published for the British Industrial Biological Research Association, 35(8), 807–820. https://doi.org/10.1016/s0278-6915(97)00052-5
Pizzorno J. (2016). Is Mold Toxicity Really a Problem for Our Patients? Part I-Respiratory Conditions. Integrative medicine (Encinitas, Calif.), 15(2), 6–10.
Pizzorno, J., & Shippy, A. (2016). Is Mold Toxicity Really a Problem for Our Patients? Part 2-Nonrespiratory Conditions. Integrative medicine (Encinitas, Calif.), 15(3), 8–14.
Scassellati C, Galoforo AC, Bonvicini C, Esposito C, Ricevuti G. Ozone: a natural bioactive molecule with antioxidant property as potential new strategy in aging and in neurodegenerative disorders. Ageing Res Rev. 2020 Nov;63:101138. doi: 10.1016/j.arr.2020.101138. Epub 2020 Aug 15. PMID: 32810649; PMCID: PMC7428719.
Shallenberger, F. (2017). The Ozone Miracle: How You Can Harness the Power of Oxygen to Keep You and Your Family Healthy. Published by Frank Shallenberger.
About the author: Mary Genevieve Carty, MS, MHEd holds Masters degrees in Complementary and Integrative Health as well as Higher Education and is currently a doctoral student in Health Science at George Washington University’s College of Medicine and Health Science. She is passionate about holistic health and wellness, and has additional training in teaching, Reiki, and Tapping/ Emotional Freedom Technique. Her research interests include resiliency, psychoneuroimmunology, neuroplastic pain, placebo/ nocebo effect, and bioenergy therapies. The views she expresses are her own, and do not reflect any affiliation.








